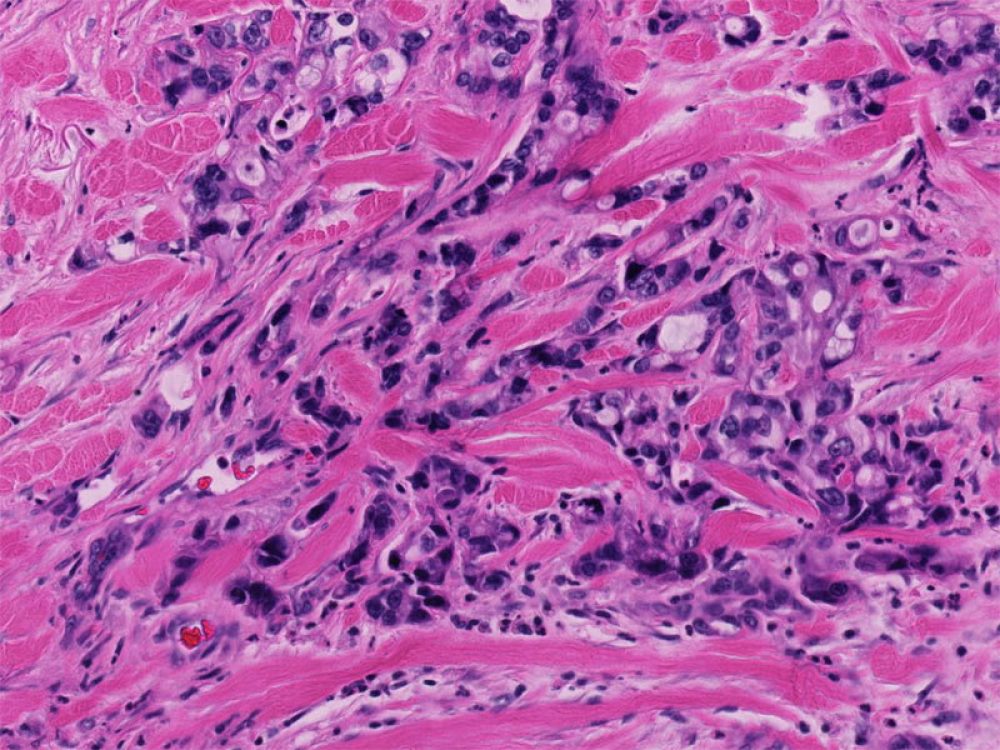

As a patient, the stage and grade of your pancreatic cancer will guide your treatment and have an impact on prognosis. Here you can learn what staging and grade mean, as well as how they are calculated.
Stage

Stage is a measure of how far the cancer has spread
Clinicians determine the size and extent of the cancer using a combination of biopsy results and clinical tests such as imaging (CT scans).
- Stages I, II, III: cancer is confined to the pancreas and the immediate surrounding area
- Stage IV: cancer has spread to other organs
Although different stages carry different prognoses, it is important to remember that the Median isn't the Message (an excellent article regarding prognoses and statistics by Stephen Jay Gould). There is always hope!
How Is Stage Determined?
The stage of a pancreatic cancer is determined by three factors: T, N, and M in a common system used by doctors to stage pancreatic tumors. A value is assigned for each of these factors based on the diagnostic test results. T, N and M values are then added up to determine stage.
T = size and local extent of the tumor
N = evidence of metastases (spread) in lymph nodes close to the pancreas
M = evidence of distant metastases (spread of the cancer far from the pancreas)
T (Tumor) ▼
T (Tumor) is assigned based on the size of the tumor (measured in centimeters) and the extent (whether or not it involves major blood vessels).
| T (Tumor) | What it Means |
|---|---|
| T0 | No evidence of primary tumor |
| Tis | In situ carcinoma |
| T1 | Tumor ≤ 2cm (2 centimeters or 0.8 inches or smaller) |
| T2 | Tumor > 2cm and ≤ 4cm in greatest dimension (tumors between 0.8 and 1.6 inches in size) |
| T3 | Tumor > 4cm in greatest dimension (tumors bigger than 1.6 inches) |
| T4 | Tumor involves the blood vessels of the celiac axis or superior mesenteric artery (unresectable primary tumor) |
| TX | Primary tumor cannot be assessed |

N (Regional Lymph Nodes) ▼
Lymph nodes are small collections of immune cells. Lymph nodes are present throughout our body. They help us fight off infections and other diseases. When pancreatic cancer spreads beyond the pancreas, cancer cells can deposit in the lymph nodes normally found around the pancreas. The "N" designation of staging refers to whether or not the cancer has spread to these lymph nodes.
| N (Regional Lymph Nodes) | What it Means |
|---|---|
| N0 | No regional lymph node metastasis (cancer has not spread to the lymph nodes) |
| N1 | Metastasis (tumor spread) in one to three lymph nodes. |
| N2 | Metastasis (tumor spread) in four or more regional lymph nodes. |
| NX | Regional lymph nodes cannot be assessed |

Metastases to lymph nodes does not automatically eliminate surgery as a treatment option. There are lymph nodes scattered throughout the body. The location of the affected lymph nodes makes a big difference.
For example, the lymph nodes right around the pancreas (in the groove between the duodenum and the pancreas) are a very common site of metastases (tumor spread). These are considered locoregional and are routinely removed during the Whipple surgical procedure. However, the spread of cancer to more distant lymph nodes, such as lymph nodes near the lungs, may mean the tumor is unresectable.
M (Metastasis) ▼

The treatment of pancreatic is different if the cancer has spread (metastasized) beyond the pancreas and beyond the lymph nodes immediately around the pancreas. In general, surgery is not pursued for patients with metastatic pancreatic cancer. Instead, most patients with metastatic pancreatic cancer are treated with combination chemotherapy.
When pancreatic cancer metastasizes, it often spreads to the liver and/or to the lungs.
- Liver - Metastases to the liver are a common finding especially with tumors in the tail and the body of the pancreas. Usually, if there is evidence of liver "mets," surgery is usually not an option. Recently, however, some surgeons do remove liver metastases ("oligometastatic disease") that have been stable or have shrunk after a year of treatment.
- Lungs - Spread (metastases) to the lungs can occur in the setting of widespread disease, or in isolation. Several studies have found that some patients with isolated lung metastases live longer than do patients with isolated liver metastases.
| M (Metastasis) | What it Means |
|---|---|
| M0 | Not metastasized |
| M1 | Metastasized |
Putting It All Together to Determine Stage ▼
Overall stage is determined by combining all the information on T, N, and M.
| Stage | T (Tumor) | N (Regional Lymph Nodes) | M (Distant Metastases) |
|---|---|---|---|
| Stage 0 | Tis | N0 | M0 |
| Stage IA | T1 | N0 | M0 |
| Stage IB | T2 | N0 | M0 |
| Stage IIA | T3 | N0 | M0 |
| Stage IIB | T1 T2 T3 | N1 N1 N1 | M0 M0 M0 |
| Stage III | T1 T2 T3 T4 | N2 N2 N2 any N | M0 M0 M0 M0 |
| Stage IV | any T | any N | M1 |
The American Cancer Society reports the 5-year survival rates for a number of cancers. The overall 5-year survival rate for pancreatic cancer is 9% (all stages). For patients with pancreatic cancer that has spread to other organs (metastasized) the reported survival rate is 3%. This increases to 10% for patients with regional disease and to 37% for patients with localized disease.
In most cases, stage is more important than grade in determining patient prognosis and treatment.
Grade
What is Grade?
The grade of a cancer can also be used to predict the aggressiveness of the cancer. Grade is a finding determined by examining the cancer under the microscope. In general, low-grade cancers look like normal ductal cells in the pancreas, while high-grade cancers look very different from normal ductal cells. The cells of high-grade cancers divide rapidly, and often have very big nuclei.
The current grading system, based on microscopic review is:
| Grade | What it Means |
|---|---|
| G1 | Low-grade. Well differentiated. Generally less aggressive. |
| G2 | Moderately differentiated |
| G3 | High-grade. Poorly differentiated. Generally more aggressive. |
| GX | Cannot be assessed (for cases in which there isn't adequate material to evaluate microscopically) |
Under the Microscope: Grades of Pancreatic Cancer
The images below are examples of a normal duct and of low-grade and high-grade pancreatic cancer; these slides are what a pathologist sees under the microscope when evaluating the grade of a pancreatic cancer.
Normal Duct ▼

Low-grade Adenocarcinoma ▼

High-grade Adenocarcinoma ▼